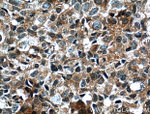
ORAI1 Antibody in Immunohistochemistry (Paraffin) (IHC (P))

Search
Proteintech
ORAI1 Monoclonal Antibody (3C12F9)
{{$productOrderCtrl.translations['antibody.pdp.commerceCard.promotion.promotions']}}
{{$productOrderCtrl.translations['antibody.pdp.commerceCard.promotion.viewpromo']}}
{{$productOrderCtrl.translations['antibody.pdp.commerceCard.promotion.promocode']}}: {{promo.promoCode}} {{promo.promoTitle}} {{promo.promoDescription}}. {{$productOrderCtrl.translations['antibody.pdp.commerceCard.promotion.learnmore']}}
产品信息
66223-1-IG
种属反应
宿主/亚型
分类
类型
克隆号
抗原
偶联物
形式
浓度
规格
纯化类型
保存液
内含物
保存条件
运输条件
产品详细信息
Immunogen sequence: MHPEPAPPP SRSSPELPPS GGSTTSGSRR SRRRSGDGEP PGAPPPPPSA VTYPDWIGQS YSEVMSLNEH SMQALSWRKL YLSRAKLKAS SRTSALLSGF AMVAMVEVQL DADHDYPPGL LIAFSACTTV LVAVHLFALM ISTCILPNIE AVSNVHNLNS VKESPHERMH RHIELAWAFS TVIGTLLFLA EVVLLCWVKF LPLKKQPGQP RPTSKPPASG AAANVSTSGI TPGQAAAIAS TTIMVPFGLI FIVFAVHFYR SLVSHKTDRQ FQELNELAEF ARLQDQLDHR GDHPLTPGSH YA (1-301 aa encoded by BC015369)
靶标信息
ORAI1 is a plasma membrane protein essential for store-operated calcium entry.
仅用于科研。不用于诊断过程。未经明确授权不得转售。
生物信息学
蛋白别名: calcium release-activated calcium channel 1; Calcium release-activated calcium channel protein 1; calcium release-activated calcium modulator 1; FLJ14466; Protein orai-1; Transmembrane protein 142A; unnamed protein product
基因别名: CRACM1; D730049H07Rik; IMD9; orai-1; ORAI1; ORAT1; RGD1311873; TAM2; TMEM142A
UniProt ID: (Human) Q96D31, (Rat) Q5M848, (Mouse) Q8BWG9
Entrez Gene ID: (Human) 84876, (Pig) 100154923, (Rat) 304496, (Mouse) 109305